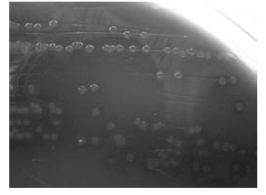

-
1.1普通高等学校“十四五”规划医学检验技术专业特色教材建设指导委员会
-
1.2总 序
-
1.3前 言
-
1.4目录
-
1.5第一章 临床微生物学实验室生物安全
-
1.5.1一、临床微生物学教学实验室规则
-
1.5.2二、临床微生物学实验室的生物安全
-
1.5.3三、临床微生物学实验室应急处理措施
-
1.6第二章 临床细菌检验的基本技术与方法
-
1.6.1实验一 细菌分离培养技术
-
1.6.1.1一、标本采集的原则和处理
-
1.6.1.2二、常用培养基的制备
-
1.6.1.3三、接种技术
-
1.6.1.4四、细菌培养及其生长现象观察
-
1.6.1.5五、思考题
-
1.6.2实验二 细菌的形态学检查
-
1.6.2.1一、染色检查法
-
1.6.2.2二、不染色检查法
-
1.6.3实验三 细菌药物敏感性实验
-
1.6.3.1一、纸片扩散法
-
1.6.3.2二、稀释法
-
1.6.3.3三、E实验法
-
1.6.3.4四、微量棋盘稀释法联合药敏实验
-
1.6.4实验四 医院感染的微生物监测
-
1.6.4.1一、常用消毒剂消毒效果的监测
-
1.6.4.2二、手、空气、物体表面等消毒效果的监测
-
1.6.4.3三、血液透析液的监测
-
1.6.4.4四、无菌用品的监测
-
1.7第三章 临床常见细菌的培养与鉴定
-
1.7.1实验五 球 菌
-
1.7.1.1一、葡萄球菌属
-
1.7.1.2二、链球菌属
-
1.7.1.3三、肠球菌属
-
1.7.1.4四、奈瑟菌属
-
1.7.1.5五、莫拉菌属
-
1.7.2实验六 肠杆菌科
-
1.7.2.1一、大肠埃希菌
-
1.7.2.2二、肺炎克雷伯菌
-
1.7.2.3三、奇异变形杆菌
-
1.7.2.4四、沙门菌属
-
1.7.2.5五、综合性实验:肠杆菌科细菌的分离鉴定
-
1.7.3实验七 非发酵菌
-
1.7.3.1一、铜绿假单胞菌
-
1.7.3.2二、嗜麦芽窄食单胞菌
-
1.7.3.3三、鲍曼不动杆菌
-
1.7.4实验八 弧菌属和气单胞菌属
-
1.7.4.1一、弧菌属
-
1.7.4.2二、气单胞菌属
-
1.7.5实验九 需氧革兰阳性杆菌
-
1.7.5.1一、蜡样芽孢杆菌
-
1.7.5.2二、阴道加特纳菌
-
1.7.6实验十 分枝杆菌属
-
1.7.6.1一、结核分枝杆菌
-
1.7.6.2二、非结核分枝杆菌
-
1.7.7实验十一 布鲁菌属
-
1.7.7.1一、临床意义
-
1.7.7.2二、布鲁菌的检验程序
-
1.7.7.3三、目的要求
-
1.7.7.4四、器材与试剂
-
1.7.7.5五、步骤与方法
-
1.7.7.6六、注意事项
-
1.7.7.7七、思考题
-
1.7.8实验十二 螺旋体
-
1.7.8.1一、梅毒螺旋体
-
1.7.8.2二、钩端螺旋体
-
1.7.9实验十三 支原体、衣原体及立克次体
-
1.7.9.1一、支原体
-
1.7.9.2二、衣原体(沙眼衣原体)
-
1.7.9.3三、立克次体
-
1.8第四章 临床常见真菌的培养与鉴定
-
1.8.1实验十四 临床真菌检验的基本技术和方法
-
1.8.1.1一、真菌的分离培养及生长现象观察
-
1.8.1.2二、真菌的形态学检查和生化鉴定
-
1.8.1.3三、真菌药物敏感性检测
-
1.8.2实验十五 临床常见真菌的鉴定
-
1.8.2.1一、表皮癣菌属
-
1.8.2.2二、假丝酵母菌属
-
1.8.2.3三、曲霉菌属
-
1.8.2.4四、隐球菌属
-
1.8.2.5五、综合性实验
-
1.9第五章 临床常见病毒的培养与鉴定
-
1.9.1实验十六 临床病毒检验的基本技术和方法
-
1.9.1.1第一节 病毒的分离培养及鉴定
-
1.9.1.2第二节 病毒的非培养鉴定技术
-
1.10第六章 设计性实验
-
1.10.1实验十七 化脓与创伤标本的微生物学检验
-
1.10.1.1一、问题背景资料
-
1.10.1.2二、实验设计提示
-
1.10.1.3三、思考题
-
1.10.2实验十八 尿液标本的微生物学检验
-
1.10.2.1一、问题背景资料
-
1.10.2.2二、实验设计提示
-
1.10.2.3三、思考题
-
1.10.3实验十九 粪便标本的微生物学检验
-
1.10.3.1一、问题背景资料
-
1.10.3.2二、实验设计提示
-
1.10.3.3三、思考题
-
1.10.4实验二十 呼吸道标本的微生物学检验
-
1.10.4.1一、上呼吸道标本的微生物学检验
-
1.10.4.2二、下呼吸道标本的微生物学检验
-
1.10.5实验二十一 生殖道标本的微生物学检验
-
1.10.5.1一、问题背景资料
-
1.10.5.2二、实验设计提示
-
1.10.5.3三、思考题
-
1.10.6实验二十二 组织标本的微生物学检验
-
1.10.6.1一、问题背景资料
-
1.10.6.2二、实验设计提示
-
1.10.6.3三、思考题
-
1.10.7实验二十三 无菌体液的微生物学检验
-
1.10.7.1一、血液与骨髓标本的微生物学检验
-
1.10.7.2二、脑脊液标本的微生物学检验
-
1.10.7.3三、穿刺液标本的微生物学检验
-
1.11第七章 研究创新型实验
-
1.11.1实验二十四 研究创新型实验
-
1.11.1.1一、进行研究创新型实验选题的基本原则
-
1.11.1.2二、课题设计
-
1.11.1.3三、项目实施
-
1.11.1.4四、项目结题
-
1.12附录
-
1.13参考文献
-
1.14彩图
1
临床微生物学检验技术实验指导